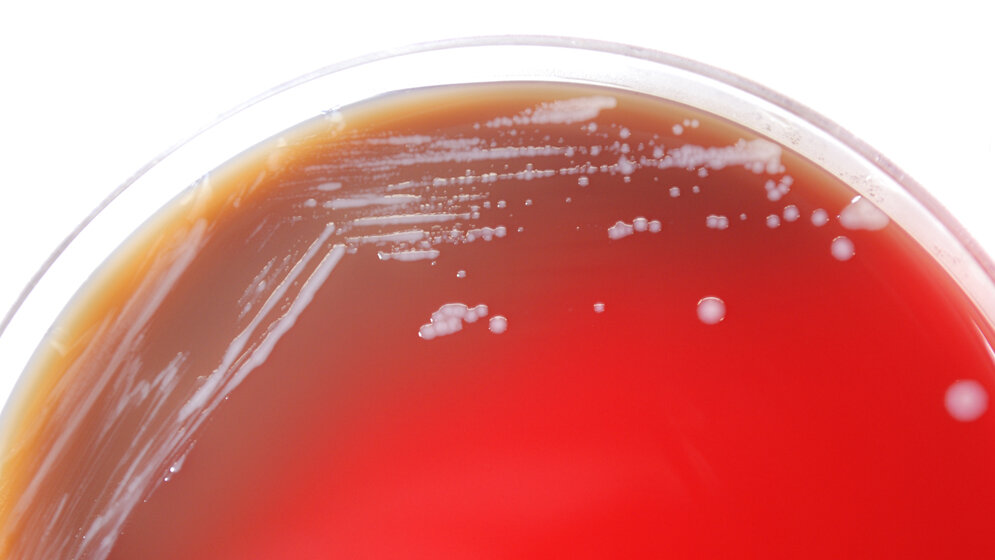
Burkholderia_mallei_auf_Blutagar_CDC_Dr_Todd_Parker_Audra_Marsh_public_domain.jpg Burkholderia mallei

Burkholderia: Wachsende Bedrohung für die globale Gesundheit
Wissenschaftler/-innen vom Leibniz-Institut für Naturstoff-Forschung und Infektionsbiologie – Hans-Knöll-Institut – (Leibniz-HKI) identifizierten von den Bakterien gebildete Substanzen, sogenannte Malleicyprole. Erste Laboruntersuchungen belegen, dass sie zu deren krankmachender Wirkung beitragen. Die Gruppe um Christian Hertweck schließt damit die Wissenslücke über die sogenannten Virulenzfaktoren der Bakterien. Die Malleicyprole wurden nun zum Leibniz-Wirkstoff des Jahres 2020 gekürt.
Eine wachsende globale Bedrohung
Sie kontaminieren den Boden oder das Wasser vor allem in Südostasien oder Nordaustralien: Die Bakterienarten Burkholderia mallei und Burkholderia pseudomallei lösen wiederaufkommende lebensbedrohliche Krankheiten wie Melioidose oder die bei Pferden vorkommende Infektion Rotz aus. Im Südosten Asiens und Norden Australiens ist Melioidose die wichtigste Ursache für eine schwere Sepsis – eine lebensbedrohliche Entzündung des gesamten Organismus – mit Sterblichkeitsraten von bis zu 40 Prozent. Antibiotika-Therapien dauern Monate an, allerdings nur mit mäßigem Erfolg, da die Erreger teilweise resistent sind. Diese Krankheiten gelten daher nicht nur als eine wachsende Bedrohung für die globale Gesundheit. Beide Bakterienarten gelten außerdem als potenzielle biologische Kampfstoffe. Kenntnisse über Virulenzfaktoren der Erreger können helfen, den Krankheitsverlauf besser zu verstehen und wirksame Mittel zur Behandlung solcher Infektionen zu entwickeln.
Wissenslücke über die Virulenzfaktoren geschlossen
„Nicht alle beobachteten krankmachenden Effekte ließen sich durch frühere Untersuchungen erklären“, so Studienleiter Christian Hertweck. Er ist Professor an der Friedrich-Schiller-Universität Jena und leitet die Abteilung Biomolekulare Chemie am Leibniz-HKI. Zur Bedeutung der aktuellen Studie meint er: „Durch die Entdeckung der neuartigen bakteriellen Wirkstoffe schlossen wir eine Wissenslücke über die Virulenzfaktoren dieser berüchtigten Krankheitserreger. Das bessere Verständnis der molekularen Grundlagen von Rotz und Melioidose bilden die Grundlage für die Entwicklung dringend benötigter Therapeutika zur Bekämpfung dieser schweren Krankheiten.“
Reaktive Vorstufen der Burkholdersäure
Dem Jenaer Team gelang es, in dem weniger krankmachenden Modellorganismus Burkholderia thailandensis ein Gencluster zu aktivieren, das im Erbgut aller Bakterien dieser pathogenen Gruppe vorhanden ist und mit Virulenz verknüpft ist. Die darin enthaltenen Gene kodieren Enzyme, die den Biosyntheseweg von bislang unbekannten Naturstoffen steuern. Als Produkt dieses komplexen Bildungsweges identifizierte die Gruppe die sogenannte Burkholdersäure. Allerdings zeigte die Säure bei Toxizitätstests keine krankmachende Wirkung. Daher suchten die Wissenschaftler/-innen nach weiteren Substanzen, deren Biosynthese durch dieses Gencluster codiert wird. Dabei entdeckten sie neue, hoch reaktive Verbindungen, denen sie den Namen Malleicyprole gaben. Das sind reaktive Vorstufen der Burkholdersäure und sowohl für Zellkulturen als auch für den häufig im Labor als Infektionsmodell verwendeten Fadenwurm Caenorhabditis elegans hochtoxisch.
Malleicyprole gehören zur Familie der weit verbreiteten Polyketide. Das Besondere an der chemischen Struktur der Malleicyprole sind Cyclopropanreste, hochgespannte Ringe aus Kohlenstoffatomen. Diese Cyclopropanreste tragen zur Reaktivität des Moleküls bei.
Der Leibniz-Wirkstoff des Jahres
Jährlich kürt der Leibniz-Forschungsverbund „Wirkstoffe und Biotechnologie“ den Leibniz-Wirkstoff des Jahres. Bereits zum 5. Mal wurden Forscher/-innen am Leibniz-HKI mit dieser Auszeichnung gewürdigt.
Trottmann F, Franke J, Richter I, Ishida K, Cyrulies M, Dahse HM, Regestein L, Hertweck C (2019): Cyclopropanol warhead in malleicyprol confers virulence of human- and animal-pathogenic Burkholderia species. Angew Chem Int Ed 58 (40), 14129-14133.
Quelle: idw/Leibniz-Institut für Naturstoff-Forschung und Infektionsbiologie - Hans-Knöll-Institut (HKI)
Artikel teilen